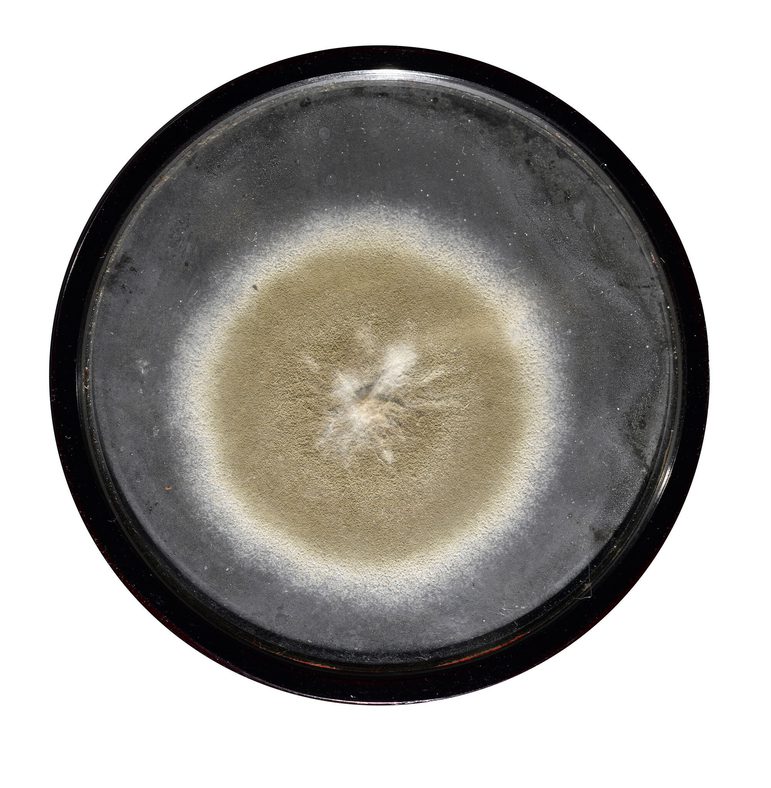

How a ceramic object fueled a medical breakthrough
News Story
A simple looking ceramic object made it possible for the first clinical trials and batch production of penicillin to take place. Its design marks a significant milestone in the history of medicine.

When was Penicillin discovered?
In 1928, Alexander Fleming made a discovery by accident when cleaning up a set of glass plates which had been used to grow a bacterium. He noticed that a mould growing on one of these plates, had inhibited the growth of the bacteria. He followed this observation up by growing the mould in a broth made of beef heart.
Fleming published his research in 1929. Two of his key conclusions were that this ‘mould juice’ could be used to remove contaminants from bacterial cultures, and it could also be used as an antiseptic to treat the surface of infected wounds.
This observation of the Penicillium notatum mould growing on the Staphylococcus aureus culture plate led to the future development of the substance we now call penicillin, a drug which has since saved millions of lives.
Sir Alexander Fleming
Sir Alexander Fleming won many awards and he often liked to give something in return. He had samples of penicillin mould mounted in frames to give as gifts. The specimen above is inscribed on the back by Alexander Fleming.
What happened next?
Ten years later, in 1938, Howard W Florey, Professor of Pathology at the University of Oxford, was looking for a substantial project for his group of research workers. This group initially included Ernst Boris Chain, a future Noble Prize winner, and Norman Heatley; more on him later.

Florey decided to research the phenomenon of ‘antibiosis’. This is the process where micro-organisms produce substances that kill or inhibit other micro-organisms. From compiling a list of about 200 known examples of antibiosis, Florey and Chain decided to investigate just three. The first of this three was the substance produced by Penicillium notatum, described by Alexander Fleming.
Dr Norman George Heatley, played a vital role in this work. His task was to produce as much ‘mould juice’ as possible for the others to study. He devised the essential step that allowed the partial purification of the drug penicillin and built the apparatus to carry out this purification process. He also developed the method to measure how much of the drug penicillin was present in any sample. This method forms the basis of the assessment of the sensitivity of micro-organisms to antibiotics to this day.
Breaking the mould
By the time the research was under way, it was wartime. Equipment was difficult to get hold of and air raids a constant threat. To produce the required 'mould juice' Heatley cultured Fleming's strain of Penicillium notatum in a variety of vessels with a large surface area. He used pie dishes, biscuit tins (obtained from Huntley & Palmers of Reading), bottles, petrol cans, and bed pans. His preferred containers were 16 lidded enamel bed pans obtained from the Radcliffe Infirmary.
Enough crude penicillin powder had been prepared by May 1940 to allow animal testing. This was successful and the next step was to prepare for clinical human trials on human patients.

Necessity driving design
Many more culture vessels were required to produce the larger quantities of mould broth needed to make enough crude penicillin powder to treat the first human patients. The war made finding them very difficult. Heatley’s preferred bed pan became unavailable, a glass design would take too long to manufacture, and so a pottery vessel was suggested.

The rectangular profile of this culture vessel was deemed the most efficient form. They could be stacked upright for sterilisation and horizontally for incubation. The inside is glazed to make it watertight, whilst the outside was left unglazed to prevent slippage during handling and to reduce production costs.
Within two months of Heatley’s initial sketch the first batch of 174 had been made and half of them were seeded with spores of the fungus on 25 December 1940.

In short supply
In total, 700 vessels were made by James Macintyre and Co. Ltd at 10 shillings (half a pound), each. The maximum output of the facility in the Dunn School was 500 litres of mould broth per week. About 2000 litres of mould broth were needed to produce enough crude penicillin powder to treat one patient. The penicillin made here was used to treat the first six patients in the Radcliffe Infirmary in Oxford in 1941.
In all, the initial animal tests and the treatment of the first six patients used about four million units of penicillin (which is now regarded as a reasonable daily dose for one individual).
Because the yield of penicillin was so poor, it was in very short supply. Penicillin is excreted unchanged through the kidneys, so in order to make the most of the very short supplies, the urine of patients being treated with it was collected and each evening it was taken back to the Dunn School for the penicillin to be extracted from it for re-use. This brings us back, full circle, to bedpans.
Penicillin in wartime
British pharmaceutical firms were unable, because of the war, to take on the production of penicillin. The results obtained from the clinical trials in Oxford were used to persuade the American government to assist in the development of the production of penicillin on an industrial scale.
Penicillin became one of the first successful drugs to treat bacterial infections, saving thousands of lives during World War II.

Thousands of glass fermentation vessels like this one were used in Glaxo (now GlaxoSmithKline) laboratories in Britain to produce penicillin. The penicillium mould was grown on the surface of a liquid filled with all the nutrients it needed. This approach was superseded by the method of growing the mould within large industrial fermenters.
For generations brought up post-penicillin, it is hard to remember that before antibiotics many infections were lethal. The development of the culture vessel is one vital piece that helped shape this new reality.


